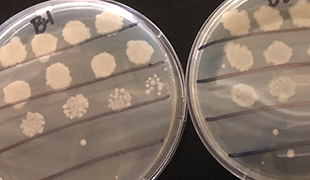

Research Opportunities for Undergraduates
CONTACT
Department of Biological Sciences
Wehr Life Sciences, 109
1428 W. Clybourn St.
Milwaukee, WI 53233
(414) 288-7355

The department of Biological Sciences has an innovative and rigorous multidisciplinary research program. Our research labs are well funded by extramural grants provided by the National Institutes of Health (NIH), National Science Foundation (NSF), Department of Energy (DOE), US Department of Agriculture (USDA) and private non-profit foundations. Faculty also have a strong collaborative network within Marquette University and with local universities including the Medical College of Wisconsin, UW-Madison and UW-Milwaukee along with several national and international collaborations.
Several labs are taking molecular and structural approaches to study key metabolic enzymes, DNA repair proteins, translation and mitochondrial factors, and oligomers in prokaryotes and eukaryotes.
Diverse labs in this research area seek to understand the forces that structure plant communities, maintain species diversity as well as study the evolutionary processes that maintain biological diversity.
This research area focuses on how microbes cope with diverse, often seemingly harsh, habitats and how they have tremendous effects on their immediate environments and the entire globe.
This highly interactive group investigate cellular and developmental processes in a variety of model systems such as C. elegans, Drosophila, Arabidopsis, Chlamydomonas, yeast and human cell lines.

Specific areas of research in this group include classical Mendelian genetics to reverse genetics with emphasis on epigenetic regulation, DNA rearrangement and microRNA biology.
The research areas of this diverse group include muscle, nerve and epithelial physiology emphasizing molecular and systems physiology with emphasis on neurotransmitters, muscle, sleep and circadian biology.